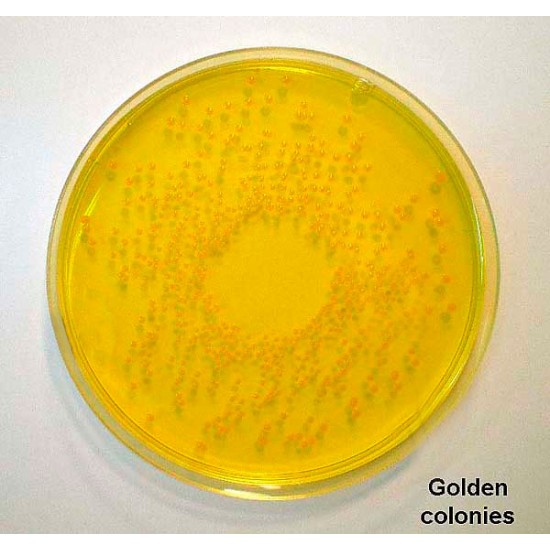
Mannitol Salt Agar (Chapman Agar) 500 G
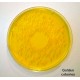
Mannitol Salt Agar (Chapman Agar) 500 G

Mannitol Salt Agar (Chapman Agar) 500 G
154.00 SAR
400.40 SAR
Ex Tax: 154.00 SAR
- Stock: In Stock
- Model: Scharlab
- SKU: 01-116-500
Product Details TCBS Agar (B/S)(Thiosulfate Citrate Bile Salts Sucrose Agar)
Concentration 89.08 gm/lit.
Part D
Storage : 8 to 25°C (Cool &..
454.78 SAR
Ex Tax:395.46 SARProduct Overview39930
SS Agar (Salmonella Shigella Agar)Concentration 60.02 gm/lit.
Part D
Storage : 8 to 25°C (Cool & dry area)
S..
500.83 SAR
Ex Tax:435.50 SAR

